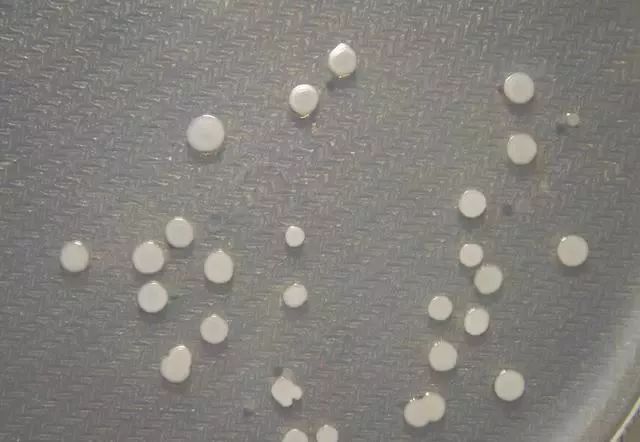
3.jpg

您好,欢迎来到幸运飞艇168体彩开奖官网官方网站!
您好,欢迎来到幸运飞艇168体彩开奖官网官方网站!



电话:400-686-0766
手机:400-686-0766
地址:高唐县晏高收费站南
生物有机肥中的所谓生物到底是些什么“生物”。
五、巨大芽孢杆菌

【作用机理】
1、巨大芽孢杆菌在生长繁殖过程中能产生大量的有机酸,可将土壤中难溶的含磷物质分解或溶解,并转化成易被植物吸收的磷元素,提高磷元素的利用率。
2、巨大芽孢杆菌分泌的一种蛋白质, 对多种农作物有害真菌有强烈的拮抗作用。
3、巨大芽孢杆菌可迅速在土壤中繁殖,成为优势菌群,控制根系的营养和其它资源,致使病原菌在相当程度上丧失生存空间和条件;使植物有关组织细胞壁增厚、纤维化、木质化程度提高,并在表皮层外形成角质双硅层,形成一道阻止病菌侵袭的屏障。
【主要功效】
1、提高土壤肥力,可将土壤中难溶的磷钾分解出来,转变为作物可吸收的磷钾化合物,使土壤中的营养元素供应增加。
2、提高肥料使用率,促进植物吸收养分,提高肥效,其代谢产生的聚麸胺酸具有较强的保水、保肥能力。
3、防治植物病害发生,对棉花立枯病菌、小麦纹枯病菌、全蚀病菌、茄假单胞杆菌、枯萎病菌、黄萎病菌、白叶枯病菌、根瘤镰刀病菌都有较强的抑制作用。
4、施用到烟叶上对提高烟叶发酵增香效果独特。
【使用范围】农业种植、生产解磷解钾肥料、生物有机肥等。
六、胶冻样芽孢杆菌

【作用机理】
分解硅酸盐和铝硅酸盐及其他矿石中的含钾矿物,具有溶磷、释钾和固氮功能,并释放出可溶性钙、硫、镁、铁、锌、钼、锰等中微量元素的作用,既增进了土壤肥力,又为作物提供了可吸收利用的全面营养元素。同时能在生长繁殖过程中产生有机酸、氨基酸、多糖等有利于植物吸收和利用的物质。在土壤中繁殖后,分泌植物生长刺激素及多种酶,以增强作物对一些病害的抵抗力,能抑制其他病原菌的生长。菌体灰分中的钾含量在33%以上,菌体内的钾可在菌体死亡后游离出来,可被植物直接吸收利用。
【主要功效】
1、能改良土壤、疏松板结、均衡养分、提高地力,活化土壤成份、提高土壤保水保肥能力,有效遏制土壤退化、改良盐碱地。
2、在其代谢过程中还产生赤霉素、吲哚乙酸、细胞分裂素等多种生理活性物质和氨基酸类物质,可同比增加作物叶绿素含量16-18%,显著增强作物光合作用,促进作物根系发达和生长健壮,增强作物抗寒、抗旱、抗病和抗逆能力,提高作物产量并改善产品品质。
3、可抑制有害微生物的生长繁殖,显著减少和减轻作物土传病害和重茬病害的发生,如枯萎病、灰霉病、白粉病、疫病和线虫病。
【使用范围】农业种植、微生物肥料。
七、侧孢芽孢杆菌
1、促进植物根系生长,增强根系吸收能力,从而提高作物产量;
2、抑制植物体内外病原菌繁殖,减轻病虫害,降低农药残留;
3、改良疏松土壤,解决土壤板结现象,从而活化土壤,提高肥料利用率;
4、增强植物新陈代谢,促进光合作用和强化叶片保护膜,抵抗病原菌;
5、增强光合作用,提高化肥利用率,降低硝酸盐含量;
6、固化若干重金属,降低植物体内重金属含量。
八、胶质芽孢杆菌
1、胶质芽孢杆菌在作物根部形成有益菌群保护,有效抑制各种土传病害的发生,对重茬病害有较强抑制作用,减少农药使用。
2、解磷、解钾、固氮、活化疏松土壤、分解各种中微量元素硅钙硫硼钼锌铁等,全面补充作物营养,大幅提高肥料利用率,减少化肥用量。
3、胶质芽孢杆菌可产生赤霉素、吲哚乙酸等多种生理活性物质,使作物生长健壮,增强作物抗寒抗旱抗病和抗逆能力,对根结线虫有一定抑制作用。
4、胶质芽孢杆菌可有效预防和改善作物生理性缺素症发生,有效抑制果树的小叶、黄叶、早期落叶病、根腐病等 。
5、胶质芽孢杆菌通过释放活性物质及营养元素的协调,可提高作物产量并改善产品品质,蔬果直顺亮泽、果形端正。
最新产品